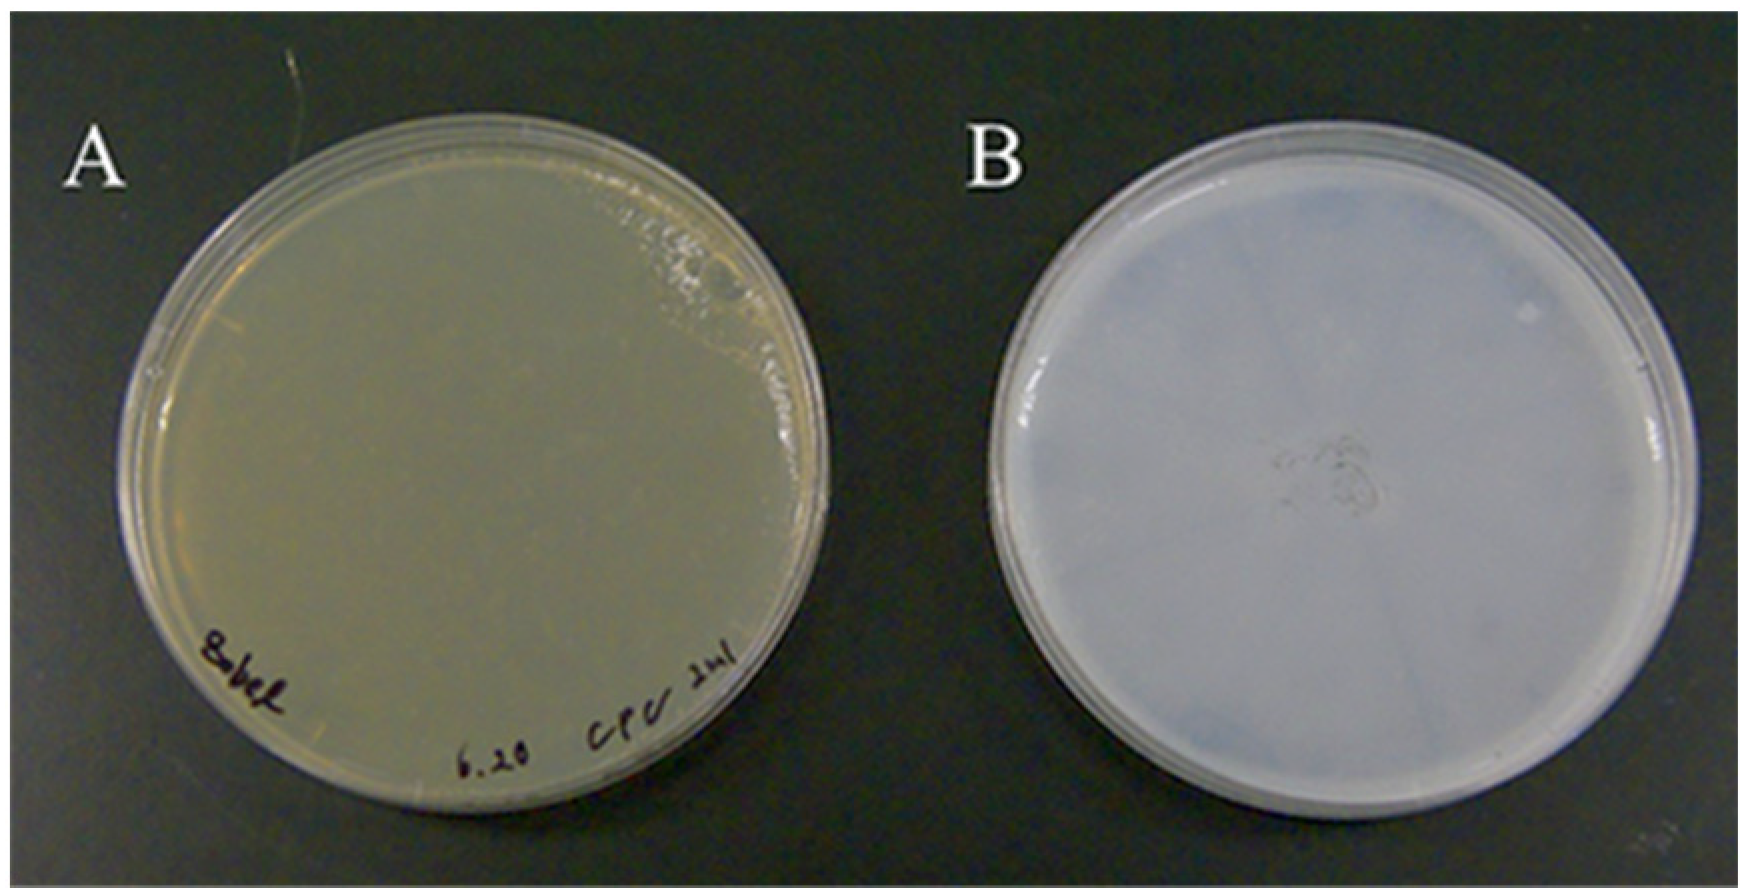
Molecules 27 03420 g001 550
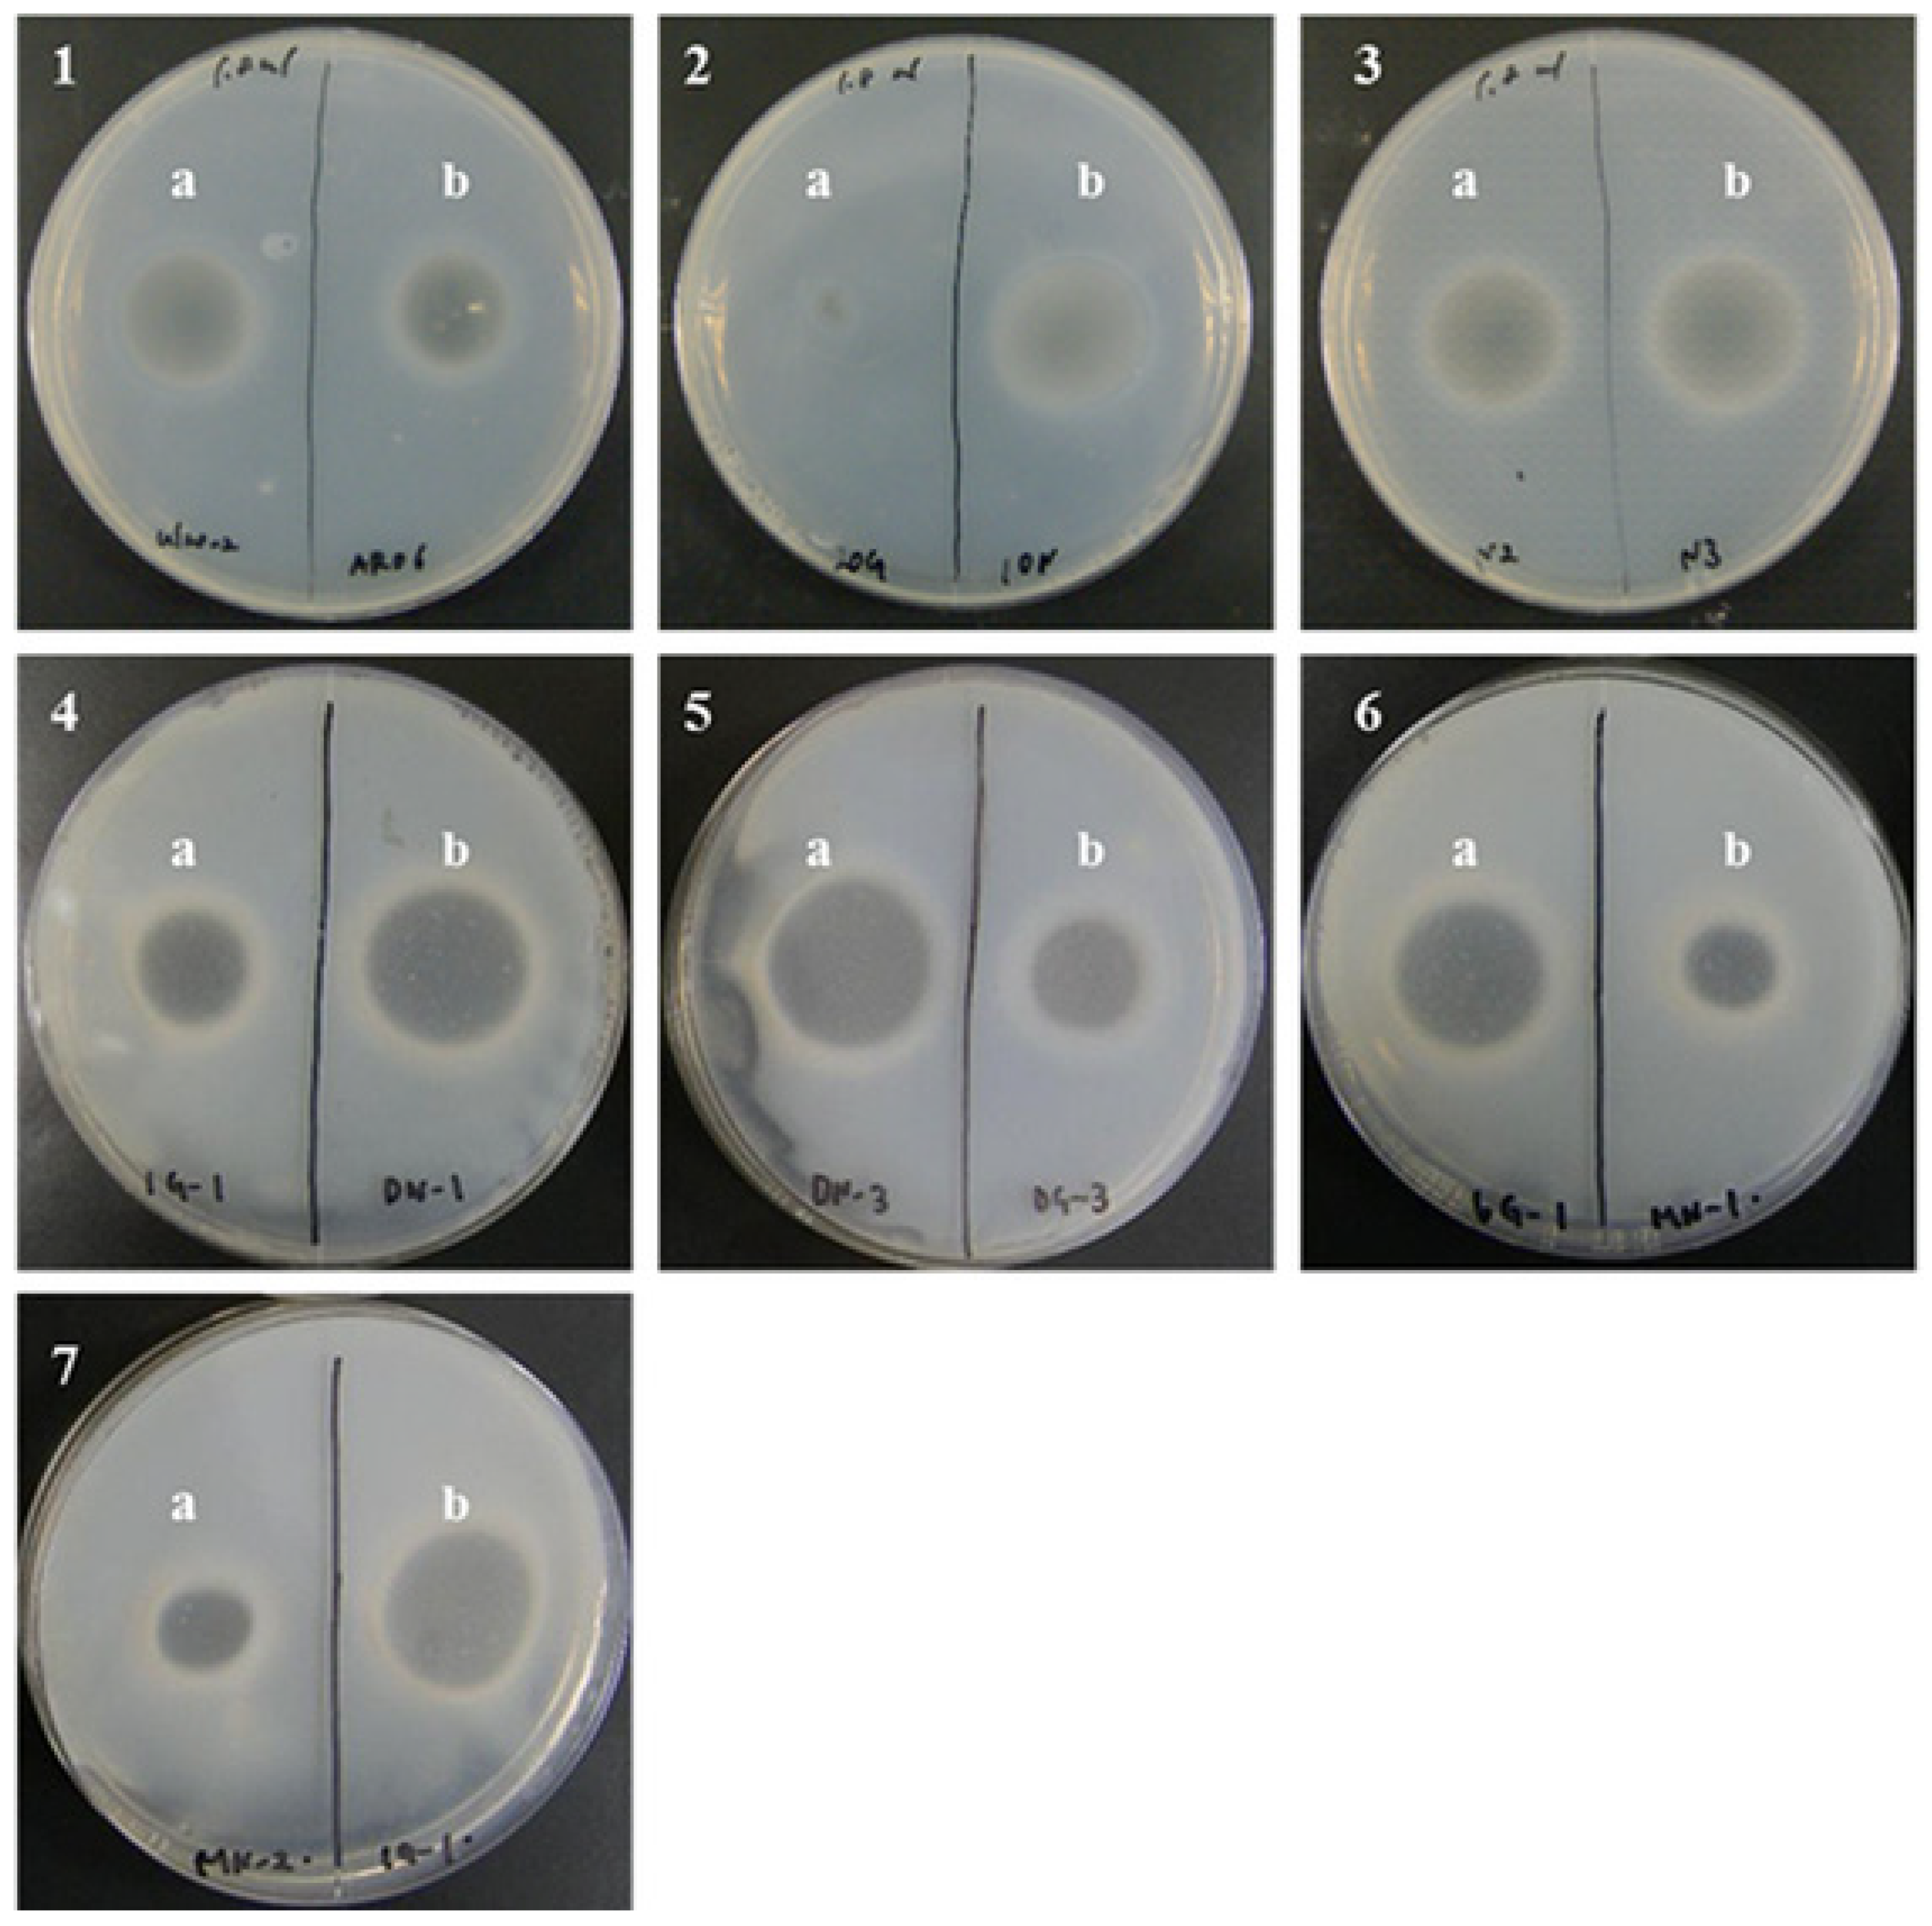
Molecules 27 03420 g003 550

Isolation, Diversity and Characterization of Ulvan-Degrading Bacteria Isolated from Marine Environments
Abstract
:1. Introduction
2. Materials and Methods
2.1. Preparation of Ulvan
2.2. Sample Collection and Preparation
2.3. Isolation of Ulvan-Degrading Bacteria from Marine Environments
2.4. Establishment of a Screening Method for Ulvan-Degrading Activity
2.5. Ulvan-Degrading Activity
2.6. Phylogenetic Analysis Based on 16S rRNA Gene Sequences
2.7. Determination of Degradation Activity by Absorbance Measurement
2.8. Identification of Ulvan-Degrading Lyase Gene Using Full-Genome Analysis of Echinicola sp. 20G
3. Results
3.1. Isolation of Ulvan-Degrading Bacteria
3.2. Phylogenetic Analysis of Isolates Using 16S rRNA Gene Sequences
3.3. Ulvan Degradation Activity
3.4. Identification of Genes Related to Ulvan Degradation in Echinicola sp. 20G
4. Discussion
5. Conclusions
Author Contributions
Funding
Institutional Review Board Statement
Informed Consent Statement
Data Availability Statement
Acknowledgments
Conflicts of Interest
Sample Availability
References
- John, R.P.; Anisha, G.S.; Nampoothiri, K.M.; Pandey, A. Micro and macroalgal biomass: A renewable source for bioethanol. Bioresour. Technol. 2011, 102, 186–193. [Google Scholar] [CrossRef] [PubMed]
- Singh, A.; Nigam, P.S.; Murphy, J.D. Renewable fuels from algae: An answer to debatable land based fuels. Bioresour. Technol. 2011, 102, 10–16. [Google Scholar] [CrossRef] [PubMed]
- Jung, K.A.; Lim, S.R.; Kim, Y.; Park, J.M. Potentials of macroalgae as feedstocks for biorefinery. Bioresour. Technol. 2013, 135, 182–190. [Google Scholar] [CrossRef] [PubMed]
- Reisky, L.; Prechoux, A.; Zuhlke, M.K.; Baumgen, M.; Robb, C.S.; Gerlach, N.; Roret, T.; Stanetty, C.; Larocqe, R.; Michel, G.; et al. A marine bacterial enzymatic cascade degrades the algal polysaccharide ulvan. Nat. Chem. Biol. 2019, 15, 803–812. [Google Scholar] [CrossRef] [PubMed] [Green Version]
- Hiroaka, M.; Ohno, M.; Kawaguchi, S.; Yoshida, G. Crossing test among floating Ulva thalli forming “green tide” in Japan. Hydrobiologia 2004, 512, 239–245. [Google Scholar] [CrossRef]
- Lahaye, M.; Robic, A. Structure and functional properties of ulvan, a polysaccharide from green seaweeds. Biomacromolecules 2007, 8, 1765–1774. [Google Scholar] [CrossRef]
- Lahaye, M.; Ray, B. Cell-wall polysaccharides from the marine green alga Ulva “rigida” (Ulvales, Chlorophyta)-NMR 287 analysis of ulvan oligosaccharides. Carbohydr. Res. 1996, 283, 161–173. [Google Scholar] [CrossRef]
- Foran, E.; Buravenkov, V.; Kopel, M.; Mizrahi, N.; Shoshani, S.; Helbert, W.; Banin, E. Functiol characterization of a novel “ulvan utilization loci” found in Alteromonas sp. LOR genome. Algal Res. 2017, 25, 39–46. [Google Scholar] [CrossRef]
- Li, Q.; Hu, F.; Zhu, B.; Ni, F.; Yao, Z. Insights into ulvan lyase: Review of source, biochemical characteristics, structure and catalytic mechanism. Crit. Rev. Biotechnol. 2020, 40, 432–441. [Google Scholar] [CrossRef]
- Kidgell, J.T.; Magnusson, M.; Nys, R.; Glasson, C.R.K. Ulvan: A systematic review of extraction, composition and function. Algal Res. 2019, 39, 101422. [Google Scholar] [CrossRef]
- Petitou, M.; Duchaussoy, P.; Lederman, I.; Choay, J.; Sinaÿ, P.; Jacquinet, J.C.; Torri, G. Synthesis of heparin fragments. A chemical synthesis of the pentasaccharide O-(2-deoxy-2-sulfamido-6-O-sulfo-alpha-D-glucopyranosyl)-(1-4)-O-(beta-D-glucopyranosyluronicacid)-(1-4)-O-(2-deoxy-2-sulfamido-3,6-di-O-sulfo-alpha-D-glucopyranosyl)-(1-4)-O-(2-O-sulfo-alpha-L-idopyranosyluronicacid)-(1-4)-2-deoxy-2-sulfamido-6-O-sulfo-D-glucopyranose decasodium salt, a heparin fragment having high affinity for antithrombin III. Carbohydr. Res. 1986, 147, 221–236. [Google Scholar] [CrossRef] [PubMed]
- Vlachou, M.; Tragou, K.; Siamidi, A.; Kikionis, S.; Chatzianagnostou, A.L.; Mitsopoulos, A.; Ioannou, E.; Roussis, V.; Tsotinis, A. Modified in vitro release of the chronobiotic hormone melatonin from matrix tablets based on the marine sulfated polysaccharide ulvan. J. Drug Deliv. Sci. Technol. 2017, 44, 41–48. [Google Scholar] [CrossRef]
- Leiro, J.M.; Castro, R.; Arranz, J.A.; Lamas, J. Immunomodulating activities of acidic sulphated polysaccharides obtained from the seaweed Ulva rigida C. Agardh. Int. Immunopharmacol. 2007, 7, 879–888. [Google Scholar] [CrossRef] [PubMed]
- Mao, W.; Zang, X.; Li, Y.; Zhang, H. Sulfated polysaccharides from marine green algae Ulva conglobata and their anticoagulant activity. J. Appl. Phycol. 2006, 18, 9–14. [Google Scholar] [CrossRef]
- Jaulneau, V.; Lafitte, C.; Jacquet, C.; Fournier, S.; Salamagne, S.; Briand, X.; Esquerré-Tugayé, M.T.; Dumas, B. Ulvan, a sulfated polysaccharide from green algae, activates plant immunity through the jasmonic acid signaling pathway. BioMed Res. Int. 2010, 2010, 525291. [Google Scholar] [CrossRef] [Green Version]
- Paulert, R.; Talamini, V.; Cassolato, J.E.F.; Duarte, M.E.R.; Noseda, M.D.; Smania, A.; Stadnik, M.J. Effects of sulfated polysaccharide and alcoholic extracts from green seaweed Ulva fasciata on anthracnose severity and growth of common bean (Phaseolus vulgaris L.). J. Plant Dis. Prot. 2009, 116, 263–270. [Google Scholar] [CrossRef]
- Kamimura, Y.; Hashiguchi, K.; Nagata, Y.; Saka, Y.; Yoshida, M.; Makino, Y.; Amano, H. Inhibitory Effects of Edible Green Algae Monostroma nitidum on Glycemic Responses. Nippon Shokuhin Kagaku Kogaku Kaishi 2010, 57, 441–445. [Google Scholar] [CrossRef]
- Ivanova, V.; Rouseva, R.; Kolarova, M.; Serkedjieva, J.; Rachev, R.; Manolova, N. Isolation of a polysaccharide with antiviral effect from Ulva lactuca. Prep. Biochem. Biotechnol. 1994, 24, 83–97. [Google Scholar] [CrossRef]
- Yip, V.L.Y.; Varrot, A.; Davies, G.J.; Rajan, S.S.; Yang, X.; Thompson, J.; Anderson, W.F.; Withers, S.G. An unusual mechanism of glycoside hydrolysis involving redox and elimination steps by a family 4 beta-glycosidase from Thermotoga maritima. J. Am. Chem. Soc. 2004, 126, 8354–8355. [Google Scholar] [CrossRef]
- Collen, P.N.; Sassi, J.F.; Rogniaux, H.; Marfaing, H.; Helbert, W. Ulvan lyases isolated from the Flavobacteria Persicivirga ulvanivorans are the first members of a new polysaccharide lyase family. J. Biol. Chem. 2011, 286, 42063–42071. [Google Scholar] [CrossRef] [Green Version]
- Kopel, M.; Helbert, W.; Henrissat, B.; Doniger, T.; Banin, E. Draft Genome Sequence of Pseudoalteromonas sp. Strain PLSV, an Ulvan-Degrading Bacterium. Genome Announc. 2014, 2, e00793-14. [Google Scholar] [CrossRef] [Green Version]
- Salinas, A.; French, C.E. The enzymatic ulvan depolymerisation system from the alga-associated marine flavobacterium Formosa agariphila. Algal Res. 2017, 27, 335–344. [Google Scholar] [CrossRef]
- He, C.; Muramatsu, H.; Kato, S.; Ohnishi, K. Characterization of an Alteromonas long-type ulvan lyase involved in the degradation of ulvan extracted from Ulva ohnoi. Biosci. Biotechnol. Biochem. 2017, 81, 2145–2151. [Google Scholar] [CrossRef] [PubMed] [Green Version]
- Shivaji, S.; Reddy, G.S. Phylogenetic analyses of the genus Glaciecola: Emended description of the genus Glaciecola, transfer of Glaciecola mesophila, G. agarilytica, G. aquimarina, G. arctica, G. chathamensis, G. polaris and G. psychrophila to the genus Paraglaciecola gen. nov. as Paraglaciecola mesophila comb. nov., P. agarilytica comb. nov., P. aquimarina comb. nov., P. arctica comb. nov., P. chathamensis comb. nov., P. polaris comb. nov. and P. psychrophila comb. nov., and description of Paraglaciecola oceanifecundans sp. nov., isolated from the Southern Ocean. Int. J. Syst. Evol. Microbiol. 2014, 64, 3264–3275. [Google Scholar] [CrossRef] [PubMed]
- Thompson, C.C.; Thompson, F.L.; Vicente, A.C.; Swings, J. Phylogenetic analysis of vibrios and related species by means of atpA gene sequences. Int. J. Syst. Evol. Microbiol. 2007, 57, 2480–2484. [Google Scholar] [CrossRef]
- Nedashkovskaya, O.I.; Kim, S.B.; Vancanneyt, M.; Lysenko, A.M.; Shin, D.S.; Park, M.S.; Lee, K.H.; Jung, W.J.; Kalinovskaya, N.I.; Mikhailov, V.V.; et al. Echinicola pacifica gen. nov., sp. nov., a novel flexibacterium isolated from the sea urchin Strongylocentrotus intermedius. Int. J. Syst. Evol. Microbiol. 2006, 56 Pt 5, 953–958. [Google Scholar] [CrossRef]
- Nedashkovskaya, O.I.; Kim, S.B.; Han, S.K.; Rhee, M.S.; Lysenko, A.M.; Rohde, M.; Zhukova, N.V.; Frolova, G.M.; Mikhailov, V.V.; Bae, K.S. Algibacter lectus gen. nov., sp. nov., a novel member of the family Flavobacteriaceae isolated from green algae. Int. J. Syst. Evol. Microbiol. 2004, 54, 1257–1261. [Google Scholar] [CrossRef] [Green Version]
- Ulaganathan, T.; Boniecki, M.T.; Foran, E.; Buravenkov, V.; Mizrachi, N.; Banin, E.; Helbert, W.; Cygler, M. New ulvan-degrading polysaccharide lyase family: Structure and catalytic mechanism suggests convergent evolution of active site architecture. ACS Chem. Biol. 2017, 12, 1269–1280. [Google Scholar] [CrossRef]
- Coste, O.; Malta, E.J.; Lopez, J.C.; Catalina, F.D. Production of sulfated oligosaccharides fromthe seaweed Ulva sp. using a new ulvan-degrading enzymatic bacterial crude extract. Algal Res. 2015, 10, 224–231. [Google Scholar] [CrossRef]
- Qin, H.M.; Xu, P.; Guo, Q.; Cheng, X.; Gao, D.; Sun, D.; Zhu, Z.; Lu, F. Biochemical characterization of a novel ulvan lyase from Pseudoalteromonas sp strain PLSV. RSC Adv. 2018, 8, 2610–2615. [Google Scholar] [CrossRef] [Green Version]
- Reisky, L.; Stanetty, C.; Mihovilovic, M.D.; Schweder, T.; Hehemann, J.H.; Bornscheuer, U.T. Biochemical characterization of an ulvan lyase from the marine flavobacterium Formosa agariphila KMM 3901T. Appl. Microbiol. Biotechnol. 2018, 102, 6987–6996. [Google Scholar] [CrossRef] [PubMed]
- Ulaganathan, T.; Banin, E.; Helbert, W.; Cygler, M. Structural and functional characterization of PL28 family ulvan lyase NLR48 from Nonlabens ulvanivorans. J. Biol. Chem. 2018, 293, 11564–11573. [Google Scholar] [CrossRef] [Green Version]
- Konasani, V.R.; Jin, C.; Karlsson, N.G.; Albers, E. A novel ulvan lyase family with broad-spectrum activity from the ulvan utilisation loci of Formosa agariphila KMM 3901. Sci. Rep. 2018, 8, 1–11. [Google Scholar] [CrossRef] [PubMed] [Green Version]
- Ulaganathan, T.S.; Helbert, W.; Kopel, M.; Banin, E.; Cygler, M. Structure–function analyses of a PL24 family ulvan lyase reveal key features and suggest its catalyticmechanism. J. Biol. Chem. 2018, 239, 4026–4036. [Google Scholar] [CrossRef] [Green Version]
- Qi, H.M.; Zhao, T.T.; Zhang, Q.B.; Li, Z.; Zhao, Z.; Xing, R. Antioxidant activity of different molecular weight sulfated polysaccharides from Ulva pertusa Kjellm (Chlorophyta). J. Appl. Phycol. 2005, 17, 527–534. [Google Scholar] [CrossRef]
- Mann, A.J.; Hahnke, R.L.; Huang, S.; Werner, J.; Xing, P.; Barbeyron, T.; Huettel, B.; Stüber, K.; Reinhardt, R.; Harder, J.; et al. The genome of the alga-associated marine flavobacterium Formosa agariphila KMM 3901T reveals a broad potential for degradation of algal polysaccharides. Appl. Environ. Microbiol. 2013, 79, 6813–6822. [Google Scholar] [CrossRef] [Green Version]
- Gao, J.; Du, C.; Chi, Y.; Zuo, S.; Ye, H.; Wang, P. Cloning, expression, and characterization of a new PL25 family ulvan lyase from marine bacterium Alteromonas sp.: A321. Mar. Drugs 2019, 17, 568. [Google Scholar] [CrossRef] [Green Version]

| Source | PL Family | Products | Product Composition |
|---|---|---|---|
| Alteromonas sp. KUL 17 | PL24 | DP2,4,6 | - |
| Glaciecola sp. KUL 10 | PL24 | - | - |
| Alteromonas sp. KUL 42 | PL24 | - | - |
| Alteromonas sp. LOR 107 | PL24 | DP2,4 | ∆UA-R3S |
| Pseudoalteromonas sp. PLSV 3875 | PL24 | DP2,4 | ∆UA-R3S-IdoA-R3S |
| Pseudoalteromonas. PLSV 3925 | PL24 | DP2,4 | ∆UA-R3S-Xyl-R3S |
| Alteromonas sp. LOR 61 | PL24 | DP2,4 | |
| Pseudoalteromonas sp. PLSV 3936 | PL25 | DP2,4 | ∆UA-R3S |
| Alteromonas sp. LOR 29 | PL25 | DP2,4 | ∆UA-R3S-Xyl-R3S |
| Nonlabens ulvanivorans NLR 492 | PL25 | DP2,4 | |
| Alteromonas sp. A 321 | PL25 | DP2,4 | ∆GlcA-Rha3S, ∆GlcA-Rha3S-Xyl-Rha3S, ∆-Rha3S |
| Formosa agariphila KMM 3901 | PL28 | DP2-6 | R3S-xyl-R3S, ∆-Rha3S-Xyl-Rha3S, ∆-Rha3S-xyl-Rha3S-xyl-Rha3S |
| Formosa agariphila KMM 3901 | PL28 | DP2,4 | - |
| Nonlabens ulvanivorans NLR48 | PL28 | DP2,4 | ∆-Rha3S |
| Nonlabens ulvanivorans NLR42 | PL28 | DP2,4 | ∆UA-R3S-Xyl-R3S |
| Formosa agariphila KMM 3901 | PL37 | DP2,4 | ∆-Rha3S, ∆-Rha3S-Xyl-Rha |
| Formosa agariphila KMM 3901 | PL40 | - | - |
| Samples (Sample Code) | Depth | Locater | Sample Date | Isolates |
|---|---|---|---|---|
| Ulva (uL) | 0 m | 34°44′32″ N, 136°31′48″ E | May 2018 | ul20-2 |
| Surface seawater (M) | 0 m | 34°44′32″ N, 136°31′48″ E | May 2019 | MN2, MN3, MN-1, MN-2, 10N, 20G |
| Sediment MK6 point (D) | 20 m | 34°41′11″ N, 137°10′08″ E | May 2019 | DN-1, DN-3, DG-3 |
| Bottom seawater MK 1 point (1) | 20 m | 34°44′30″ N, 137°03′57″ E | May 2019 | 1G-1, 1G-1-2 |
| Bottom seawater MK6 point (6) | 20 m | 34°41′11″ N, 137°10′08″ E | May 2019 | 6G-1 |
Publisher’s Note: MDPI stays neutral with regard to jurisdictional claims in published maps and institutional affiliations. |
© 2022 by the authors. Licensee MDPI, Basel, Switzerland. This article is an open access article distributed under the terms and conditions of the Creative Commons Attribution (CC BY) license (https://creativecommons.org/licenses/by/4.0/).
Share and Cite
Tanaka, R.; Kurishiba, Y.; Miyake, H.; Shibata, T. Isolation, Diversity and Characterization of Ulvan-Degrading Bacteria Isolated from Marine Environments. Molecules 2022, 27, 3420. https://doi.org/10.3390/molecules27113420
Tanaka R, Kurishiba Y, Miyake H, Shibata T. Isolation, Diversity and Characterization of Ulvan-Degrading Bacteria Isolated from Marine Environments. Molecules. 2022; 27(11):3420. https://doi.org/10.3390/molecules27113420
Chicago/Turabian StyleTanaka, Reiji, Yu Kurishiba, Hideo Miyake, and Toshiyuki Shibata. 2022. "Isolation, Diversity and Characterization of Ulvan-Degrading Bacteria Isolated from Marine Environments" Molecules 27, no. 11: 3420. https://doi.org/10.3390/molecules27113420
APA StyleTanaka, R., Kurishiba, Y., Miyake, H., & Shibata, T. (2022). Isolation, Diversity and Characterization of Ulvan-Degrading Bacteria Isolated from Marine Environments. Molecules, 27(11), 3420. https://doi.org/10.3390/molecules27113420






